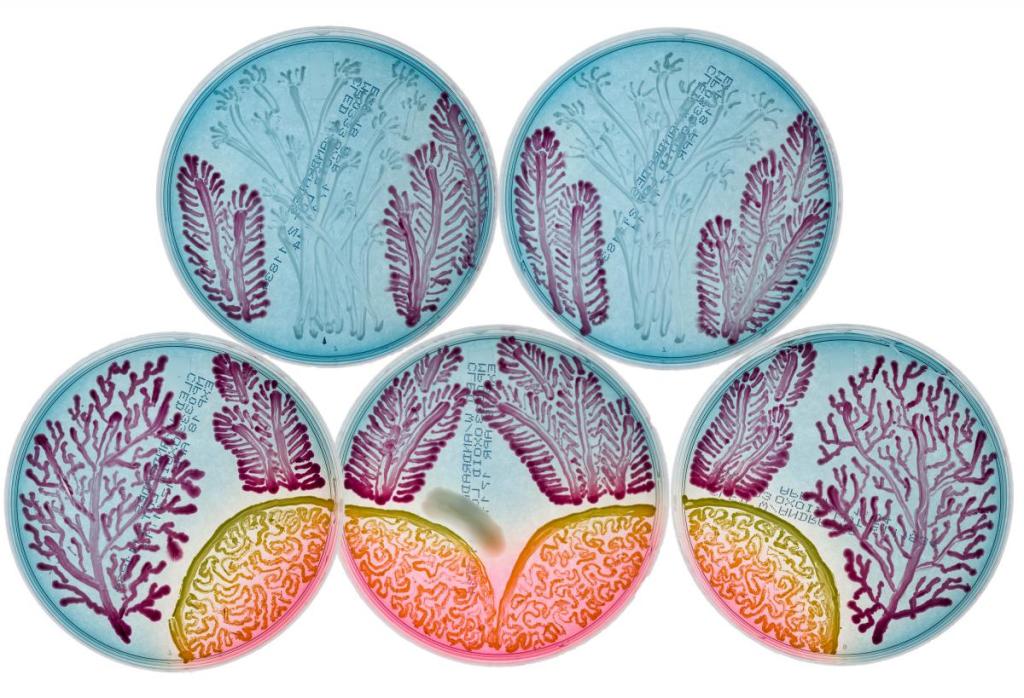

My name is Taylor Tramontano, a graduate from the University of Miami with a Bachelor of Science in Biology seeking to apply my STEM background to the world of veterinary medicine. This page is dedicated to documenting my experiences with biology, research, and adorable animals through images and explanations! Follow along to watch how I tailor veterinary science to my personal interests in preparation for veterinary school.
A WordPress.com site